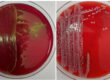

Parasites have developed different survival strategies. In addition to the oral ingestion of infectious stages, other transmission routes also play a role in completing the development cycle. This knowledge is important for developing control strategies. Age and type of housing (outdoor cat, purely indoor cat) also have an influence on the probability of infection. Feeding raw meat or innards can also increase the risk of infection. Outdoor cats can also eat wild rodents and carrion. Transmission to humans is also possible with some cat parasites. The knowledge of infection possibilities and prevention makes it possible to minimise the risk for humans and animals, but diagnostics and a suitable choice of therapy are also important topics.
The gastrointestinal parasites of cats that have several or special transmission routes or that have a zoonotic potential in Europe are described in more detail below.
Toxocara cati
Toxocara cati is a roundworm that can be found in cats (Figure 1). There are various ways in which a cat can become infected and thus complete and maintain the development cycle of the parasite.
Transmission routes in the cat:
- orally by ingestion of embryonated eggs
- galactogenic transmission
- paratenic hosts ‒ feeding on:
– rodents and birds
– undercooked meat
-
Fig. 1: Toxocara cati egg
Image source: Laboklin
-
Fig. 2: Toxoplasma gondii – oocysts
Image source: Laboklin
In addition to the oral ingestion of embryonated eggs from the environment, galactogenic transmission also plays a role in Toxocara cati. An infection in the last trimester of pregnancy or at the beginning of lactation can result in larvae being transmitted to the puppies in the milk. Cats can also become infected through paratenic hosts. Paratenic hosts are animals in which a parasite resides and survives, but does not develop further. In the case of Toxocara cati, rodents and birds, for example, act as paratenic hosts that have become infected with eggs. By eating infected rodents, the cat ingests the larvae, which then develop further in the cat’s body. Inadequately heated meat from farm animals (e.g. sheep, pigs, poultry) can also contain infective larvae. In contrast to Toxocara canis in dogs, there is no prenatal infection.
Zoonosis
Humans can also act as a paratenic host or false host. They can become infected, but the development and completion of the development cycle does not occur as the parasite cannot be ingested by the final host.
Transmission routes in humans:
- orally by ingestion of embryonated eggs from the environment
- contaminated water/food
- consumption of paratenic hosts (undercooked meat)
Humans can become infected by ingesting sand or soil (e.g. sandpits, parks) where cats have defecated. Contaminated water or vegetables, for example, are also described. The significance of eating raw liver or other offal from farm animals as a route of infection is unknown in Europe. There is a lack of knowledge about the significance of food-borne transmission compared to other transmission routes. Serological tests for the detection of antibodies against Toxocara in humans usually show cross-reactivity and therefore do not differentiate between Toxocara canis and Toxocara cati.
After ingestion of infectious eggs, larvae start to migrate in the human body. The clinical pictures vary depending on the localisation affected:
- Larva migrans visceralis
- ocular larva migrans
- concealed toxocarosis
- neurotoxocarosis
Prevention:
- Minimise environmental contamination with eggs
- Collect faeces and dispose of properly
- Treatment of infected animals
- Repeated treatment of the female and her kittens during lactation and after weaning
- Pregnant queen
- to prevent lactogenic transmission of larvae to kittens (e.g. emodepside once approx. 7 days before expected birth)
- Lactating queen
- at the same time as the 1st treatment of the kittens
- Kittens
- from the age of 3 weeks
- every 2 weeks until 2 weeks after weaning
- then monthly until the age of 6 months
- Pregnant queen
- Avoid infection through food
- no insufficiently heated or non-frozen meat
- no prey animals
- Fencing of playgrounds, covering of sandpits, regular application of new sand or change 1 to 2x per year
- Hand hygiene
- Washing up products from the garden
- Avoidance of geophagia in children
Toxascaris leonina
Toxascaris leonina is also a roundworm in cats. Infection only occurs through oral ingestion of eggs or by eating paratenic hosts.
Ancylostoma tubaeforme
In the case of the hookworm Ancylostoma tubaeforme, the L1 larva develops after excretion of the eggs in the faeces, which hatches from the egg and develops into the L3 larva. The infective L3 larva is ingested orally by the cat. Percutaneous infection is also possible. In contrast to Ancylostoma caninum in dogs, Ancylostoma tubaeforme plays a subordinate role in larva migrans cutanea in humans.
Isospora
Isospora felis and Isospora rivolta are strictly hostspecific. Cats usually become infected by ingesting sporulated oocysts from the environment. Paratenic hosts such as rodents and ruminants can harbour infective stages (dormozoites) intracellularly in various organs.
Toxoplasma gondii
Toxoplasma gondii belongs to the protozoa (Figure 2). The cat is the definitive host. Mammals, birds and humans can act as intermediate hosts. During their lifetime, many cats become infected. Antibodies in up to 74% of adult cats have been described in the population. After the initial infection, the animals excrete oocysts for 7 – 21 days. In case of re-infection, oocysts are not usually excreted.
Transmission routes in the cat:
- sporulated oocysts in the environment
- intrauterine through tachyzoites (rarely lactogenic)
- Bradyzoites in the meat (tissue cysts) of prey or when fed raw meat
Zoonosis
Humans can become infected via various routes.
Transmission routes in humans:
- Ingestion of oocysts from the environment (soil, water, uncooked vegetables)
- Consumption of undercooked or raw meat
- Contact with infectious cat faeces
- Intrauterine transmission to the foetus on first infection during pregnancy
The consumption of undercooked or raw meat, especially pork, sheep and goat, which contains tissue cysts, is a possible source of infection. The ingestion of oocysts from soil, water or vegetables also plays a role in transmission. Pregnant women should take particular care when gardening. Transmission to the foetus during pregnancy is rare (< 0.1%). Cat faeces with oocysts are only infectious when the oocysts have sporulated, a process that takes around 48 hours. Indoor cats that are not fed raw meat pose no risk to humans. Women who have already been infected before pregnancy and therefore have a positive antibody titre are not at risk of transmitting the disease to their unborn child.
Prevention
- Daily cleaning of litter trays to prevent sporulation of oocysts (after approx. 48 hours)
- Disposal of faeces in the residual waste and not in the toilet (reduction of environmental contamination)
- Feeding cats with prepared feed
- Consumption of sufficiently heated (70 °C core temperature for 5 – 10 minutes) or previously frozen (- 20 °C for at least 2 days) meat
- Hygiene when handling raw meat in the kitchen
- Hygiene when gardening (e.g. wearing gloves)
Giardias
Giardia duodenalis belongs to the protozoa and infects a wide range of different mammals and humans. Transmission occurs via the oral ingestion of infectious cysts from the environment.
Zoonosis
There are currently 8 genotypes with different host spectra. Assemblages A and B show a broad host range and therefore have zoonotic potential. In contrast, the other assemblages appear to be hostspecific. In cats the genotype F is dominating and the zoonotically relevant assemblages only being detected to a small extent. In humans, on the other hand, the zoonotic assemblages dominate. Giardia infections in humans are subject to mandatory reporting in Germany, with 3291 cases registered in 2019 (0.004% of the German population). The low incidence of 4 per 100,000 inhabitants is clearly evident. Of the 2303 cases with information on the country of infection, 51% of the infections were attributable to foreign countries, which makes giardiasis a classic travel-associated disease. According to an analysis by the RKI from 2013, most people were infected in Asia (22%), followed by Africa and America.
The risk of transmission from cats to humans is estimated to be very low.
Prevention:
- Removal of infectious faeces
- Strict hygiene measures, especially in countries with an increased risk of infection such as Asia
- Hand hygiene
- Avoidance of possibly contaminated water or food
- Boiling or filtering water from the environment
Echinococcus multilocularis
Infection with the tapeworm Echinococcus multilocularis occurs only occasionally in cats. Cats become infected by eating rodents, which act as intermediate hosts. The worm burden in a cat infection is low and only a few eggs are excreted, which signifies a low zoonotic potential in contrast to foxes and dogs. The infective eggs are extremely resistant and can survive in the environment for up to 8 months. Vectors such as flies, but also objects such as tyres, shoes and animal paws can contribute to the spreading of the eggs.
Transmission routes in the cat:
- Ingestion of intermediate hosts (small mammals) with infective stages (metacestodes) in organs
Zoonosis
In humans, Echinococcus multilocularis causes alveolar echinococcosis. Humans become infected through direct contact with infected animals or through contaminated water, soil or food such as fruit and mushrooms.
Transmission routes in humans:
- oral ingestion of the eggs
- direct contact with infected final host
- contaminated food, water, soil
Prevention for people in endemic areas:
- Washing or – even better – cooking low-growing wild and cultivated plants and fallen fruit before consumption
- Washing hands after contact with soil
- Caution when handling potentially infected foxes and other end hosts
Dipylidium caninum
Dipylidium caninum, the cucumber tapeworm, requires fleas, sucking lice or chewing lice as an intermediate host to complete its development cycle. By eating an infected flea, the cat ingests the infective stages (cysticercoids), which enables the tapeworm to develop into an adult worm in the cat’s intestinal tract. If eggs or tapeworm segments are detected, the cat should also be treated for fleas and it is advisable to carry out an environmental treatment. The zoonotic risk for humans is very low and occurs through the oral ingestion of infected fleas.
An intermediate host is also always required for other types of tapeworm in cats and for the cat liver fluke Opisthorchis felineus (intermediate host: fish, humans may also be the final host). Other tapeworm species include, for example, Taenia taeniaeformis (intermediate host: rodents), Diphyllobothrium latum (intermediate host: fish, humans may also be the final host), Spirometra erinaceieuropaei (intermediate host: amphibians, reptiles, birds and small mammals, humans are very rarely the accidental host), Mesocestoides spp. (intermediate host: amphibians, reptiles, birds and small mammals, humans are very rarely the accidental host).
Dr Jacqueline Csokai